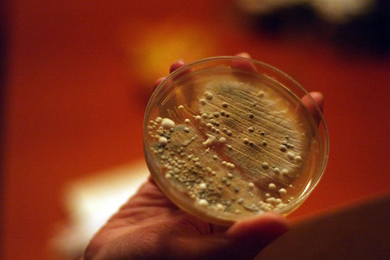

FEAR/CHEES = BACTERIA/SMELL (work in progress), 2011
Sissel Tolaas in collaboration with Christina Agapakis
We live in a biological world completely surrounded by rich communities of micro-organisms, but also in a cultural world that emphasizes total antisepsis. "Sanitized and pasteurised for your protection" is the antiseptic slogan of our times that slowly leads us to sensory death. Although it goes without saying that not all smells and bacteria can be pleasant, the consequences of our hyper-sanitation could be that we eventually engage with none at all. Smells, bacteria, and bacteria that produce smells, surround us all the time. Chemical detection is an ancient biological communication tool used by bacteria and animals alike. Smells and bacteria are a crucial component in defining, understanding, and orienting ourselves within any given environment.
The intersection of our interests in smell and microbial communities led us to focus on cheese as a model organism. Many of the most aromatic cheeses are hosts to species of bacteria that are closely related to the bacteria responsible for the characteristic smells of human armpits or feet. Can knowledge and tolerance of bacterial cultures in our food improve the tolerance of bacteria on our body and in other aspects of our life? How do human cultures cultivate and value bacterial cultures on cheeses and fermented foods? How will synthetic biology change with a better understanding of how species of bacteria work together in nature, as opposed to the sterile cultures of the lab? Will we be able to re-engineer bacterial communities as readily as we can add or delete genes to and from E. coli? How will synthetic biology change our relationship to the microbial communities that surround us?
NOTHING STINKS ONLY THINKING MAKES IT SO.
"Smell [..] is a highly elusive phenomenon. Odours, unlike colors, for instance, cannot be named – at least not in European languages. ‘It smells like...', we have to say when describing an odour, groping to express our smell experience by means of metaphors. Nor can odours be recorded: there is no effective way of either capturing scents or storing them over time. In the realm of olfaction, we must make do with descriptions and recollections." (Constance Classen, David Howes, and Anthony Synnott, Aroma: The cultural history of smell (UK: Routledge, 1994), p.3)
Re_Search Lab
The Re_Search Lab was founded in January 2004 as a laboratory for research on smell, the olfactory and smell-communication. The lab is situated in Berlin and is part of the Tolaas studio, a workspace where interdisciplinary projects are developed, researched and executed. These projects all involve smell, odour and fragrance in various ways, shapes or forms, and can be conceptual, scientific and creative in nature.
The Lab is supported by International Flavors and Fragrances (IFF), a leading creator and manufacturer of flavours and fragrances, which provides the lab with all its necessary ingredients and technical equipment. The Re_Search Lab is a research situation in which highly qualified professionals from different disciplines meet for the purpose of creating new and innovative approaches to the social role of smell. The lab’s unique mix of research projects with conceptual work on smell and the olfactory attracts companies, institutes, universities and individual clients. The Re_Search Lab is a 'station of dialogues', a place to establish a continuous dialogue between IFF experts and a range of other experts. The goal of the Lab is to change existing notions on noses, smells and the act of smelling and makes a perfect context to further develop the archive of smell and it's interconnected language that has been growing for nearly twenty years.
The Smell Archive
The smell archive is an archive in process since 1990. The archive today consists of 6763 distinctive smells from all over the world. Each smell emits from ‘something’. This ‘something’ is collected, hermetically preserved and canned in aluminum-boxes. The boxes all have the same shape and size.
Two devices have been developed to preserve the smells in the archive. The first has been developed to remove all oxygen from the can to isolate the smell. By doing this, only the pure smell remains and this lasts much longer. The second device was developed to allow the smells to be sampled at any time, while they remain contained in the boxes. It has a pump as well as a ventilator and can be put on top of one of the boxes to allow access to the smell inside. To do so, the device first pumps the smell into a separate chamber inside the box and then blows it out by means of the ventilator. A filter in-between the box and the device prevents the smell from disappearing.
The archive is an attempt to learn the ‘alphabet’ of smell and smelling, or in other words. Generally, we categorise smells with the subjective connotations ‘like it’ or ‘do not like it’. The smell archive tries to approach the immensely rich world of smells objectively. In this objective approach to smell, the labelling of the boxes in the archive is crucial. The labels carry information about the where, how, when, what, why, etc. of the smell-content inside the respective box. Besides this information, each box has a distinct number that refers to a story related to the smell kept inside a database on a computer. Literally every smell in the archive has a story to tell.
Besides the fact that the archive functions as a bank of information on smells, the organisation of archived smells into categories has formed the basis for a new fictional 'smell language'. Since the archive's categories are based on the objective information on the labels and inside the database, there is no need to use subjective terms such as bad and good for the categories. While experimenting with various categorization systems, names and terminologies for each of the categories gradually developed, ranging from substantives and adjectives to verbs. In this way a fictional language slowly emerged, named NASALO. This language has been growing and developing ever since.
"Each day, we breathe about 23,040 times and move around 438 cubic feet of air. It takes us about five seconds to breathe--two seconds to inhale and three seconds to exhale--and, that time, molecules of odor flood through our systems. Inhaling and exhaling, we smell odors. Smells coat us, swirl around us, enter our bodies, emanate from us. We live in a constant wash of them. Still, when we try to describe a smell, words fail us like the fabrications they are." (Diane Ackerman, A Natural History of the Senses (NY: Vintage Books, 1991), p.6-7)
NASALO
Taking into account that our societies have developed a language for colour, it is remarkable that we have not yet developed one for smell. This is why I began to invent the first words for a language of smells, the NASALO dictionary. Although I made these words up myself, they are certainly not arbitrary.
In one experiment, subjects rated a body smell as more pleasant when it was labelled 'cheddar' than when it was labelled 'body smell'. Another experiment showed that a mere label was enough to make subjects imagine a smell even when they were sniffing clean air. So how you describe what you smell has influence on how you perceive the smell. In other words, smell labels have power. That is why the words in NASALO have to be completely context-free, fantasy words.
SMELL = Information, a Tool for Communication – Navigation – Education
A deeper understanding of the sense of smell is important in order to be more conscious of the possibilities it offers and its powerful capacity. Smell can empower vision and sound or, in contrast, create new meanings, conveying meaning on its own. Smell has always been relevant. It always has the power to transform and go everywhere. It is a sense that people cannot control, cannot stop; we cannot avoid being exposed to it, as opposed to the senses of vision and hearing. In the past, cities and people offered a rich olfactory mix and had characteristic smells of the activities that were carried out. These different smells created olfactory maps, enabling people to find their way in their environment by way of smell.
What we are dealing with now is a society full of Blandscapes, areas so empty of stimuli that they lead to an alienating sense of placelessness. The revolution in civic cleanliness has been accompanied by a revolution in personal cleanliness, and this came with the drive for deodorization. Sight has become the predominant means and metaphor for discovery and knowledge. What would happen if one were able to change this?
For more then twenty years I have dedicated myself to the nose and to smell, on all levels of life. I have an archive of 6730 smells from reality, plus a professional lab archive of 2500 molecules (supported by the IFF, New York). My knowledge and expertise is in simulation – simulation through synthetic molecules of the air and smells that surround us all the time, be it body sweat or smells from particular neighbourhoods. The goal is to displace these smells, and ask questions, train tolerance and raise awareness. In other words I reveal what the industry is trying to cover up, deodorize or camouflage. To do this I have to work internationally, in an interdisciplinary collaborative fashion 365 days a year, 24 hours a day.
My work is all about making systems of smells as bases for communication. These systems can be used for the purposes of navigation, education, design, architecture, health care, and attention to the environment.
Not very much is known about the process of learning to recognize by smell, but my experience is that it is a simpler, less conscious kind of recognition than that achieved by sight or sound. We inherently associate smells with experiences; in contrast to vision, smell perception involves a more intimate relationship between the perceiver, the smell and the event. I decided to investigate this by asking a few fundamental questions:
Can I learn smells the way I learned the ABCs and 123s?
Is it possible to get rid of prejudices towards certain smells?
How can one describe and remember smells? Can smells be measured?
How can I use the information in smells?
Can an abstract smell molecule portray or convey a specific learned meaning by itself?
Can smell be an information unit combined in communication systems with other sensory information?
Can smell per se be an information unit and be used for the purposes of communication and navigation?
Using smell to train tolerance
Tolerance is the key word for a new approach to ourselves and our surroundings. We have to learn to live together in a different way. To be able to do this we have to go back to the body and learn the functions of the tools we have. A very important aspect here is that these tools are free. This process can start with the nose.
By undertaking smell walks and smell projects - of different kinds and for different purposes - with people in different parts of the world, I see that they understand their surroundings differently and more fundamentally. If people get the message through the nose, they really get the message.
SWEAT FEAR | FEAR SWEAT, 2005
The FEAR research project started in 2005 with twenty men (bodies) from twenty different parts of the world with one severe phobia in common: A fear of other people's bodies, based on different, extreme and less extreme, reasons. Each of these men were given an electronic device that was specially made for the project; a very small object that the men carried with them everywhere and all the time.
At the onset of a fear attack the men would place the device under their armpits. Subsequently, the equipment would suck the sweat in and register its molecules. The samples were then sent to the Re_search Lab in Berlin overnight (thanks to a special service provided to the project by parcel service UPC), where the original sweat samples were chemically simulated. The manufactured molecules were then 'micro-encapsulated' - a nanotechnology process in which molecules are packed together in micro units. The tiny membranes of these units rupture so easily that touching them activates the smell again.
The micro-encapsulated simulated sweat molecules were then integrated into transparent smell-neutral binders with which the gallery walls were 'painted'. By doing so, only touching the walls released the smells. The smells were all painted next to each other without any clear borders, as if one body was positioned next to the other, merely separated by numbers positioned in the left corner of each 'smell portrait'.
NASALO examples from the exhibition 'OUTSIDEIN', 2006.
AFIISH = African shops
BEETEE = concrete
BIISH = rubbish
BEESH = mixed barbeque
BMAAI = allure; bewitch; charm; magnetic
CAA = traffic
CAMECC = vehicle repair
CHEPDU = cheap furniture storage
CHIISH = Chinese shops
CLESH = clean sea
CLII = nature
CIKIN = smells from perfume and soaps that smell ok but are somehow displaced
CASCA = sweat mixed with metal of cars
DTO = mixed old perfumes
DADO = dead leaves and compost
DUSBI = dusty brick
DOCASA = kebab and perfumes
DADO = dead leaves and canalization
EER = ferrite
ENGEA = sport
FRE = wet and rainy street after a sunny day
FAATS = bad food oils
FAFEES = fast food
FEBEESH = grilled fish
FIIWAA = dirty water, channel
FIIPAA = paint-fix, printing
FREEIS = leisure
FRE = wet and rainy street after a sunny day
FIIGH = bird
GRAVI = old dead parks
GOOHISH = bulldogs and other dogs
GIISH = money
GLAASH = Bentley, Rolls Royce
GAREEN = mixed garden
GRA = hot fat meat
GJLUU = etherealising, glorifying
HISIS = horse
HOZON = countryside
HEFEE = wheat, beer
HISIS = horse
HOZON = countryside
HAQLA = urine; humid ash; some medicaments
HAQSE = citrus fruits
HAKSA = alcohol; camphor; chili; wet dust
HAKSE = pod; green beans
HAKSEII = piquant; savoury; flavoursome
HIIN = magic
INIISH = Indian kitchen
ISJ = grass
IKUNKA = fat; grease
INKUQA = butcher
IHKONKA = stinking urine
INO = cleaned asphalt and stones – antiseptic soaps
JAMP = apple-pie
JACSA = so penetrating that it disturb, like the juice of orange peel
KOOD = ice-cream
KANKALAY = smells that penetrate the air
KINKALAMIN = smells that comes with the wind from somewhere else
LEUMEMO = river Seine water and ships
LETTE = football in water, wet football
LEUMEMO = water and ships
MUUSHD = swamp area
METAN = old graveyards and old bones in the earth
MEBEESH = grilled meat
MOODO = filthy channel
MAAR = penetrating seashore smell
MORA = rusty, sweet and old
MUKLUN = flowers; food and other sorts of comfortable smells
MUKSUN = mint; parsley; tobacco and other spices; some medicament
MUQSUN = corn; lemon
MUKUN = fresh vegetables
MUQUN = raw fruits
MUELH’UN = unpleasant aromatic; sour
MUES’UN = pleasant aromatic; light; perfume; flowers; vanilla
MUES’IN = charming; delicious; dulcet; lovely; smooth; sweet
MOK’ON = fresh; raw; sour
MMZEN = bread bakery
MEETAN = old graveyards and old bones in the earth
MORA = rusty, sweet and old
MARJE = market – mixed oriental fruits and vegetables
MO’ONTIK = romantic
NIIS = natural flowers
NEEK = tobacco warehouse
OSSEE = rose bush
ONII = obvious; unmistakeable
OVEPOU = cheap heavy perfumed washing powder
OOR = lemonade
ORANJ = hot body mixed with hot engines
POL = diesel
PASSLO = ardent; burning; fervent; passionate
PLIISH = Polish shops
PIKON = dog shit
PTIISH = big polluted street with empty houses
POOWE = bouncing; effective; forceful
PUKLA = human being excrements; rotten things; the breath of a drunken person
PIISHE = importunate; intrusive; loud; obtrusive; pushful
PUKSA = skunk; fox; bad meat; dung; specific plants
PUQSA = mould; mushrooms and similar
P’OKLHA = unpleasant; unclean; sweat
P’UCLHA = dog
P’UCSA = stinking; very unpleasant
P’OKXA = mould
PUUHS = cigarettes - fresh French cigarettes
POSIER = sand, dust and street stones
QUINCALA = smelly; stinking
REEN = tree
RUSWAT = iron ports
SAFEWAA = salty water mixed with fresh water
SKUNKA = metallic smells; mouse; fish; snake; coins; humid earth
SQUNGA = dirty feet; strong fish smell
SQUNQA = unappetizing food; equipment / kitchenware used for eating
SHIIZA = canalization
SMOUBEE = pub
SUUL = old car battery, sulphide
SHEE = trash
SYNTII = plastic
SHOOTH = McDonald's
SYNCLIIS = dry-clean
SKENN = leather
SUIIS = caramel factory
STISH = exclusive stones
SMASA = sand
SSISJ = sea grass
SKUTA = vinegar and other sour smells
SQUTA = leader; sweat; open wounds; humid walls
SKIHA = fragrant; tasteful
SPIIFI = active; forceful; expressive; convincing
SQAHA = cooked food
SGAHA = burned gunpowder; firework; caustic smells
SCUNCA = stinking; fish; dirty kitchenware; rust metallic
SQU’IJA = simple but appetizing
SIEED = melancholic; gloomy; blue
SIRREE = covetable; desirable
SLEER = fascinating; beguiling
TCKOO = take away food
TARKEE = train
TARNEK = airport take of stripes, burned rubber and kerosene
TZIQU’IN = rancid (fat, butter, oil); cockroach
TARR = asphalt
TERPE = oil-paint
TIOL = lime wood
URBCAS = dry pollution of cars
URSWE = sweat and urine
UNDEGRA = metro platform: metal, tires and burned plastic
UBEET = binged; exaggerative; excessive; extravagant; farfetched
UUJ = inimitable; peerless; remarkable; singular; unique
VEBEESH = grilled vegetables
VLOO = bawdy; gross; vulgar
WOULGROU = wild grass
WOO = timber
WOONEE = fresh pallet
WIID = shore
WAAW = boat
ZOUSH = ozone
XK’AJA = verger
XKONKA = stinking; spoiled eggs
XC’UTA = sour; spicy; dazzling
© SISSEL TOLAAS
A NASALO city map (sketch for 'OUTSIDEIN', 2006)
HEFEE
HOZO KOOD
OSSEE MUUSHD ISJ METAN
SMASA STISH FAFEES TCKOO
HISIS PTIISH SKENN SUUL
RUSWAT NIIS POL WOONEE ZOUSH
TERPE MAAR CHIISH JAMP
GLAASH AFIISH OVEPOU PLIISH CHEPDU
CAA BEETEE SHEE VEBEESH LEUMEMO SSISJ
DADO CAMECC GAREEN GOOHISH WIID FIIWAA
BEESH MOODO WOULGROU
REEN CLESH FIIPAA FEBEESH SMOUBEE
HOZON MORA BIISH ENGEA INIISH
SUIIS FAATS WOO EER
GIISH FREEIS TARR GRAVI
SHOOTH SHIIZA
FRE LETTE SYNTII
TARKEE DUSBI HISIS NEEK OOR
CLII
FIIGH SYNCLIIS PIKON WAAW
SAFEWAA
© SISSEL TOLAAS